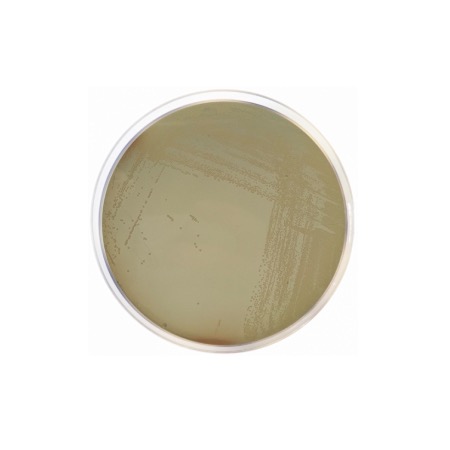
product

The medium is designed to detect the fermentation of lactose by microbial activity. It contains Meat Peptone and Beef Extract, which provide essential nitrogenous compounds, carbon, vitamins, and minerals for bacterial growth. Lactose is the fermentable carbohydrate source. Bromocresol Purple acts as a pH indicator; when lactose is fermented, organic acids are produced, lowering the pH and causing the medium to change color from purple to yellow. This visible color change, often accompanied by gas production (if Durham tubes are used), provides a clear presumptive indication of the presence of coliforms.
Advantages
- Standardized Formulation: Complies with DEV standards for water analysis, ensuring consistency in regulatory testing.
- High Sensitivity: The nutrient-rich base allows for the recovery and detection of even small numbers of lactose-fermenting bacteria.
- Clear Visual Indicator: Bromocresol purple provides a sharp color transition (yellow at pH < 5.2, purple at pH > 6.8), making interpretation straightforward.
- Versatile Application: Primarily used for water quality testing, but also applicable in the food industry for screening lactose fermenters.
- Ease of Use: Simple preparation and reliable results within a 24-48 hour incubation period.
Technical specifications
| Catalogue number |
1421 (Pack 500g: 1153) |
| Brand |
Condalab |
| Application |
Detection of lactose-degrading microorganisms / Water analysis |
| Typical Composition (g/L) |
Meat Peptone (10.0); Beef Extract (3.0); Lactose (10.0); Sodium Chloride (5.0); Bromocresol Purple (0.02) |
| Final pH (at 25 °C) |
7.2 ± 0.2 |
| Preparation |
28.0 g/L |
| Storage Temperature |
2 – 25 °C |
Available packaging options
| 1421 |
500 g plastic bottle |